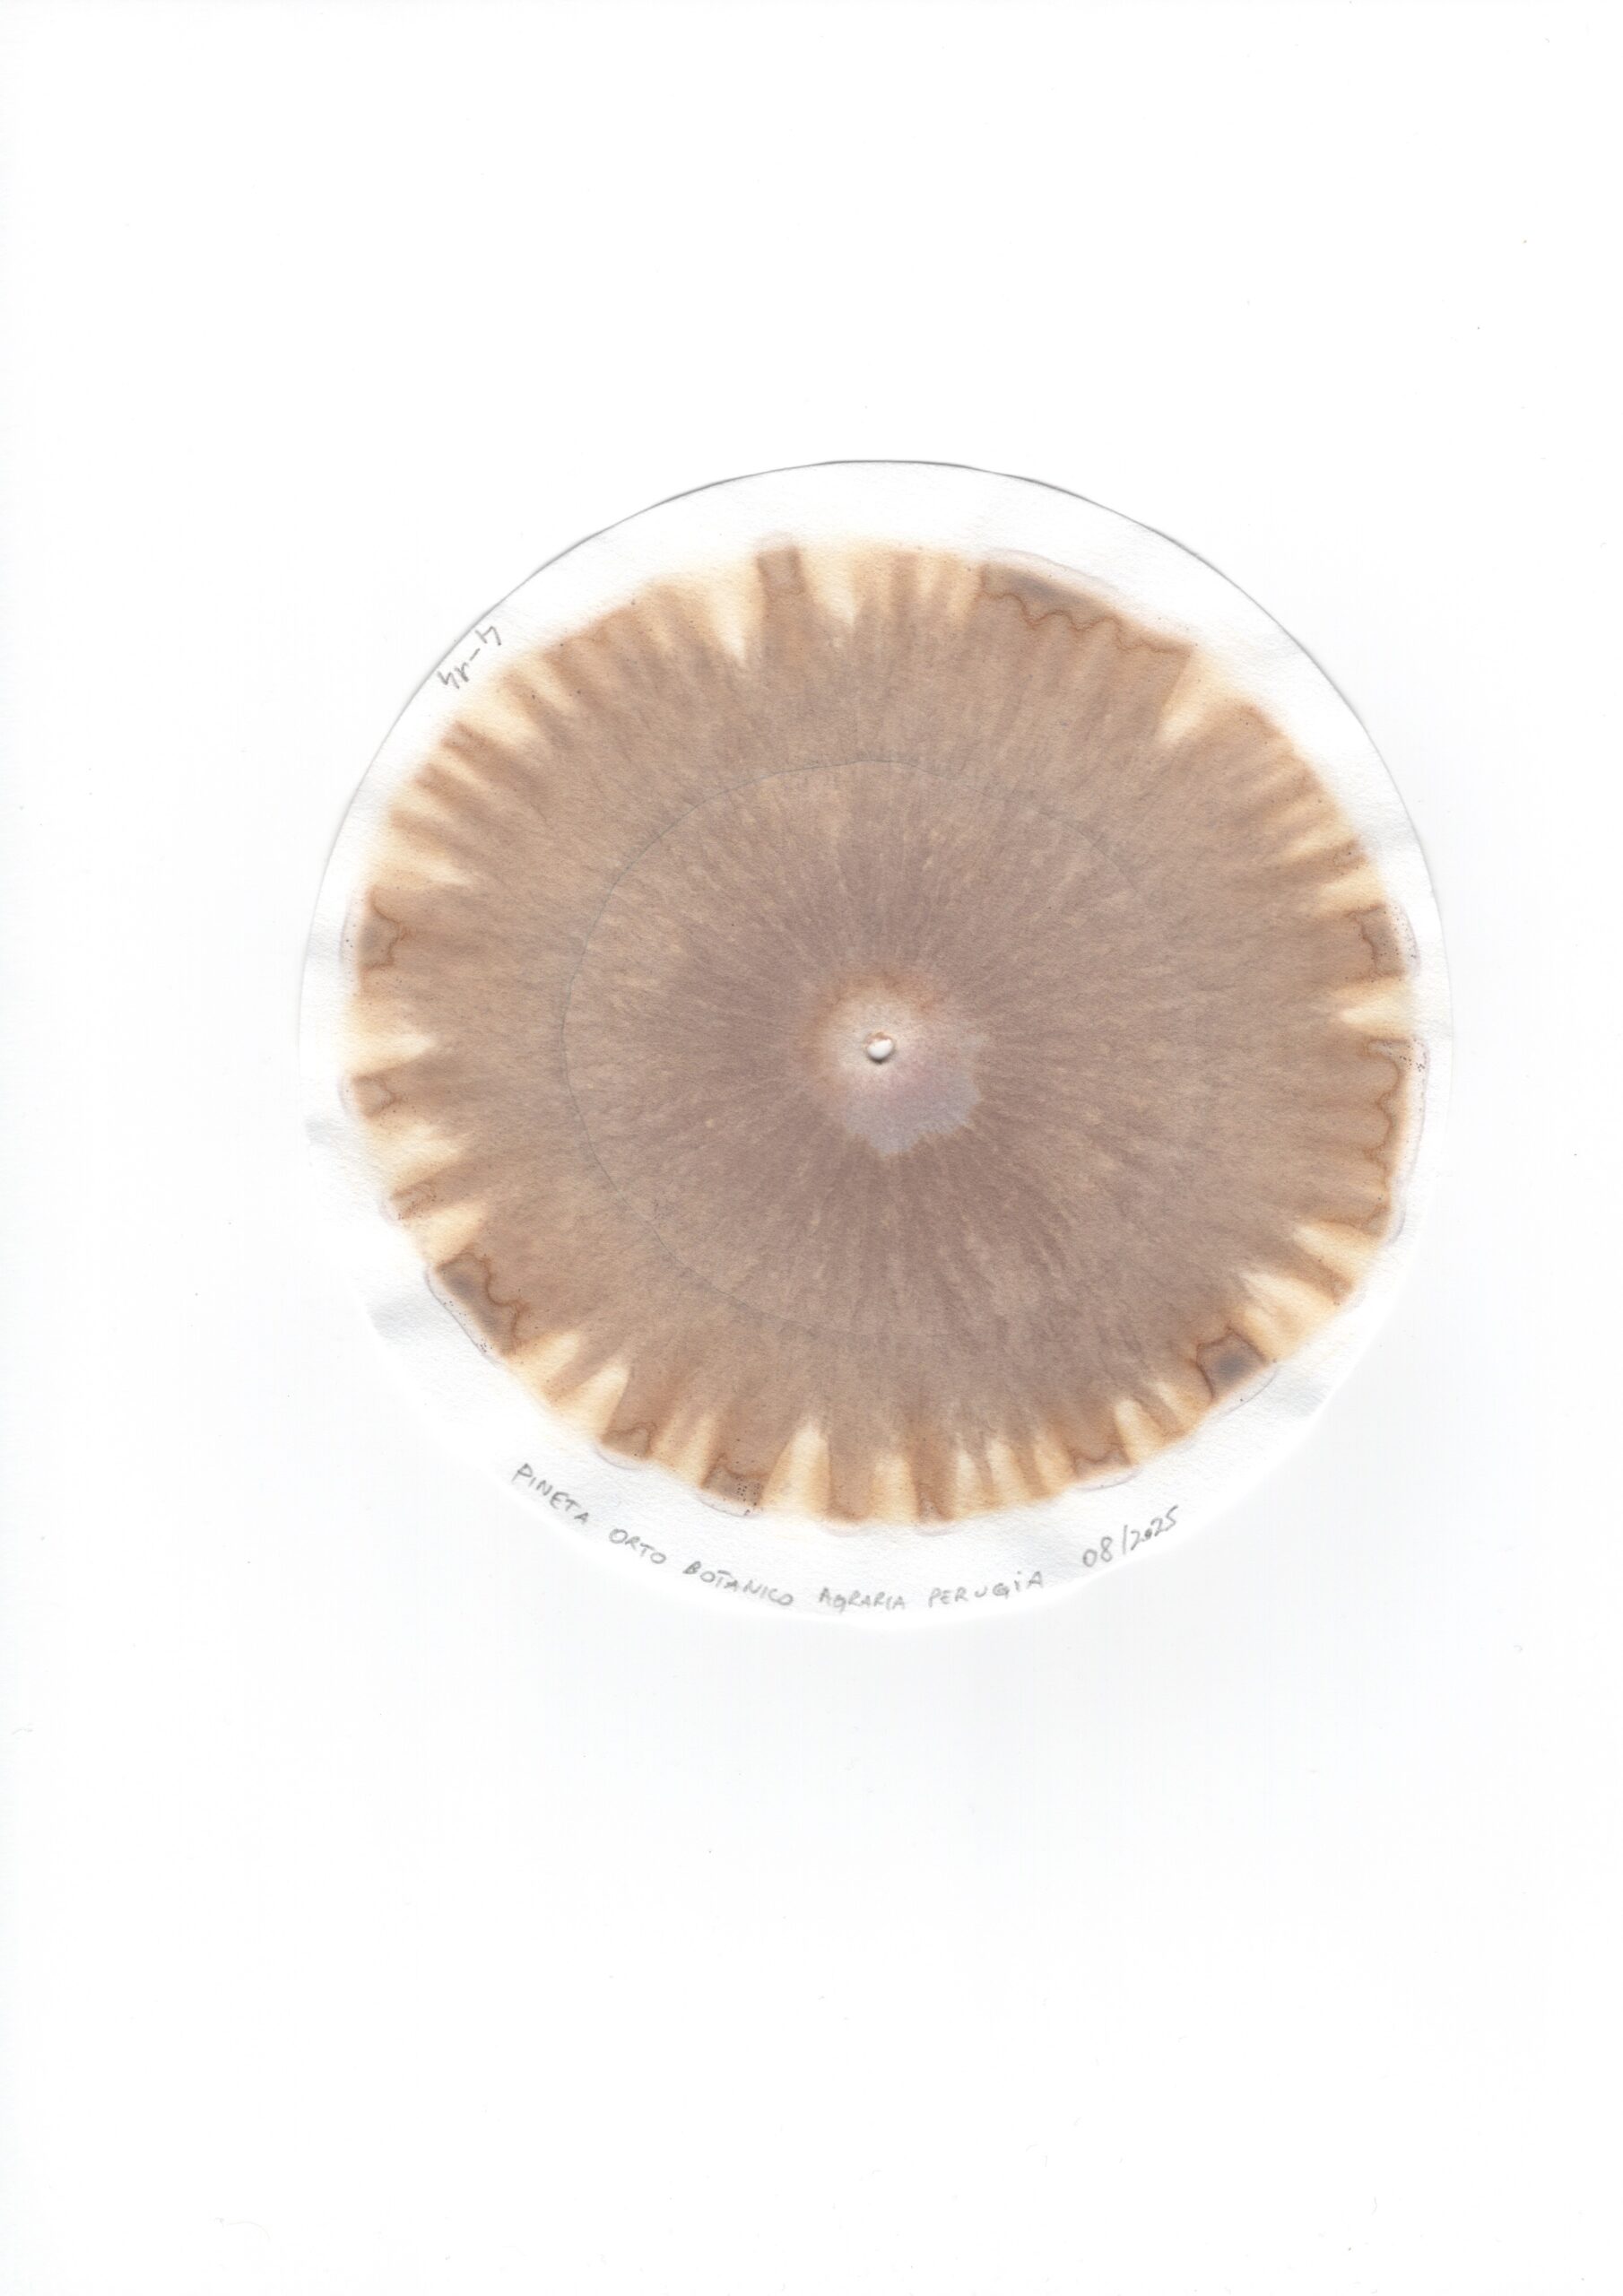
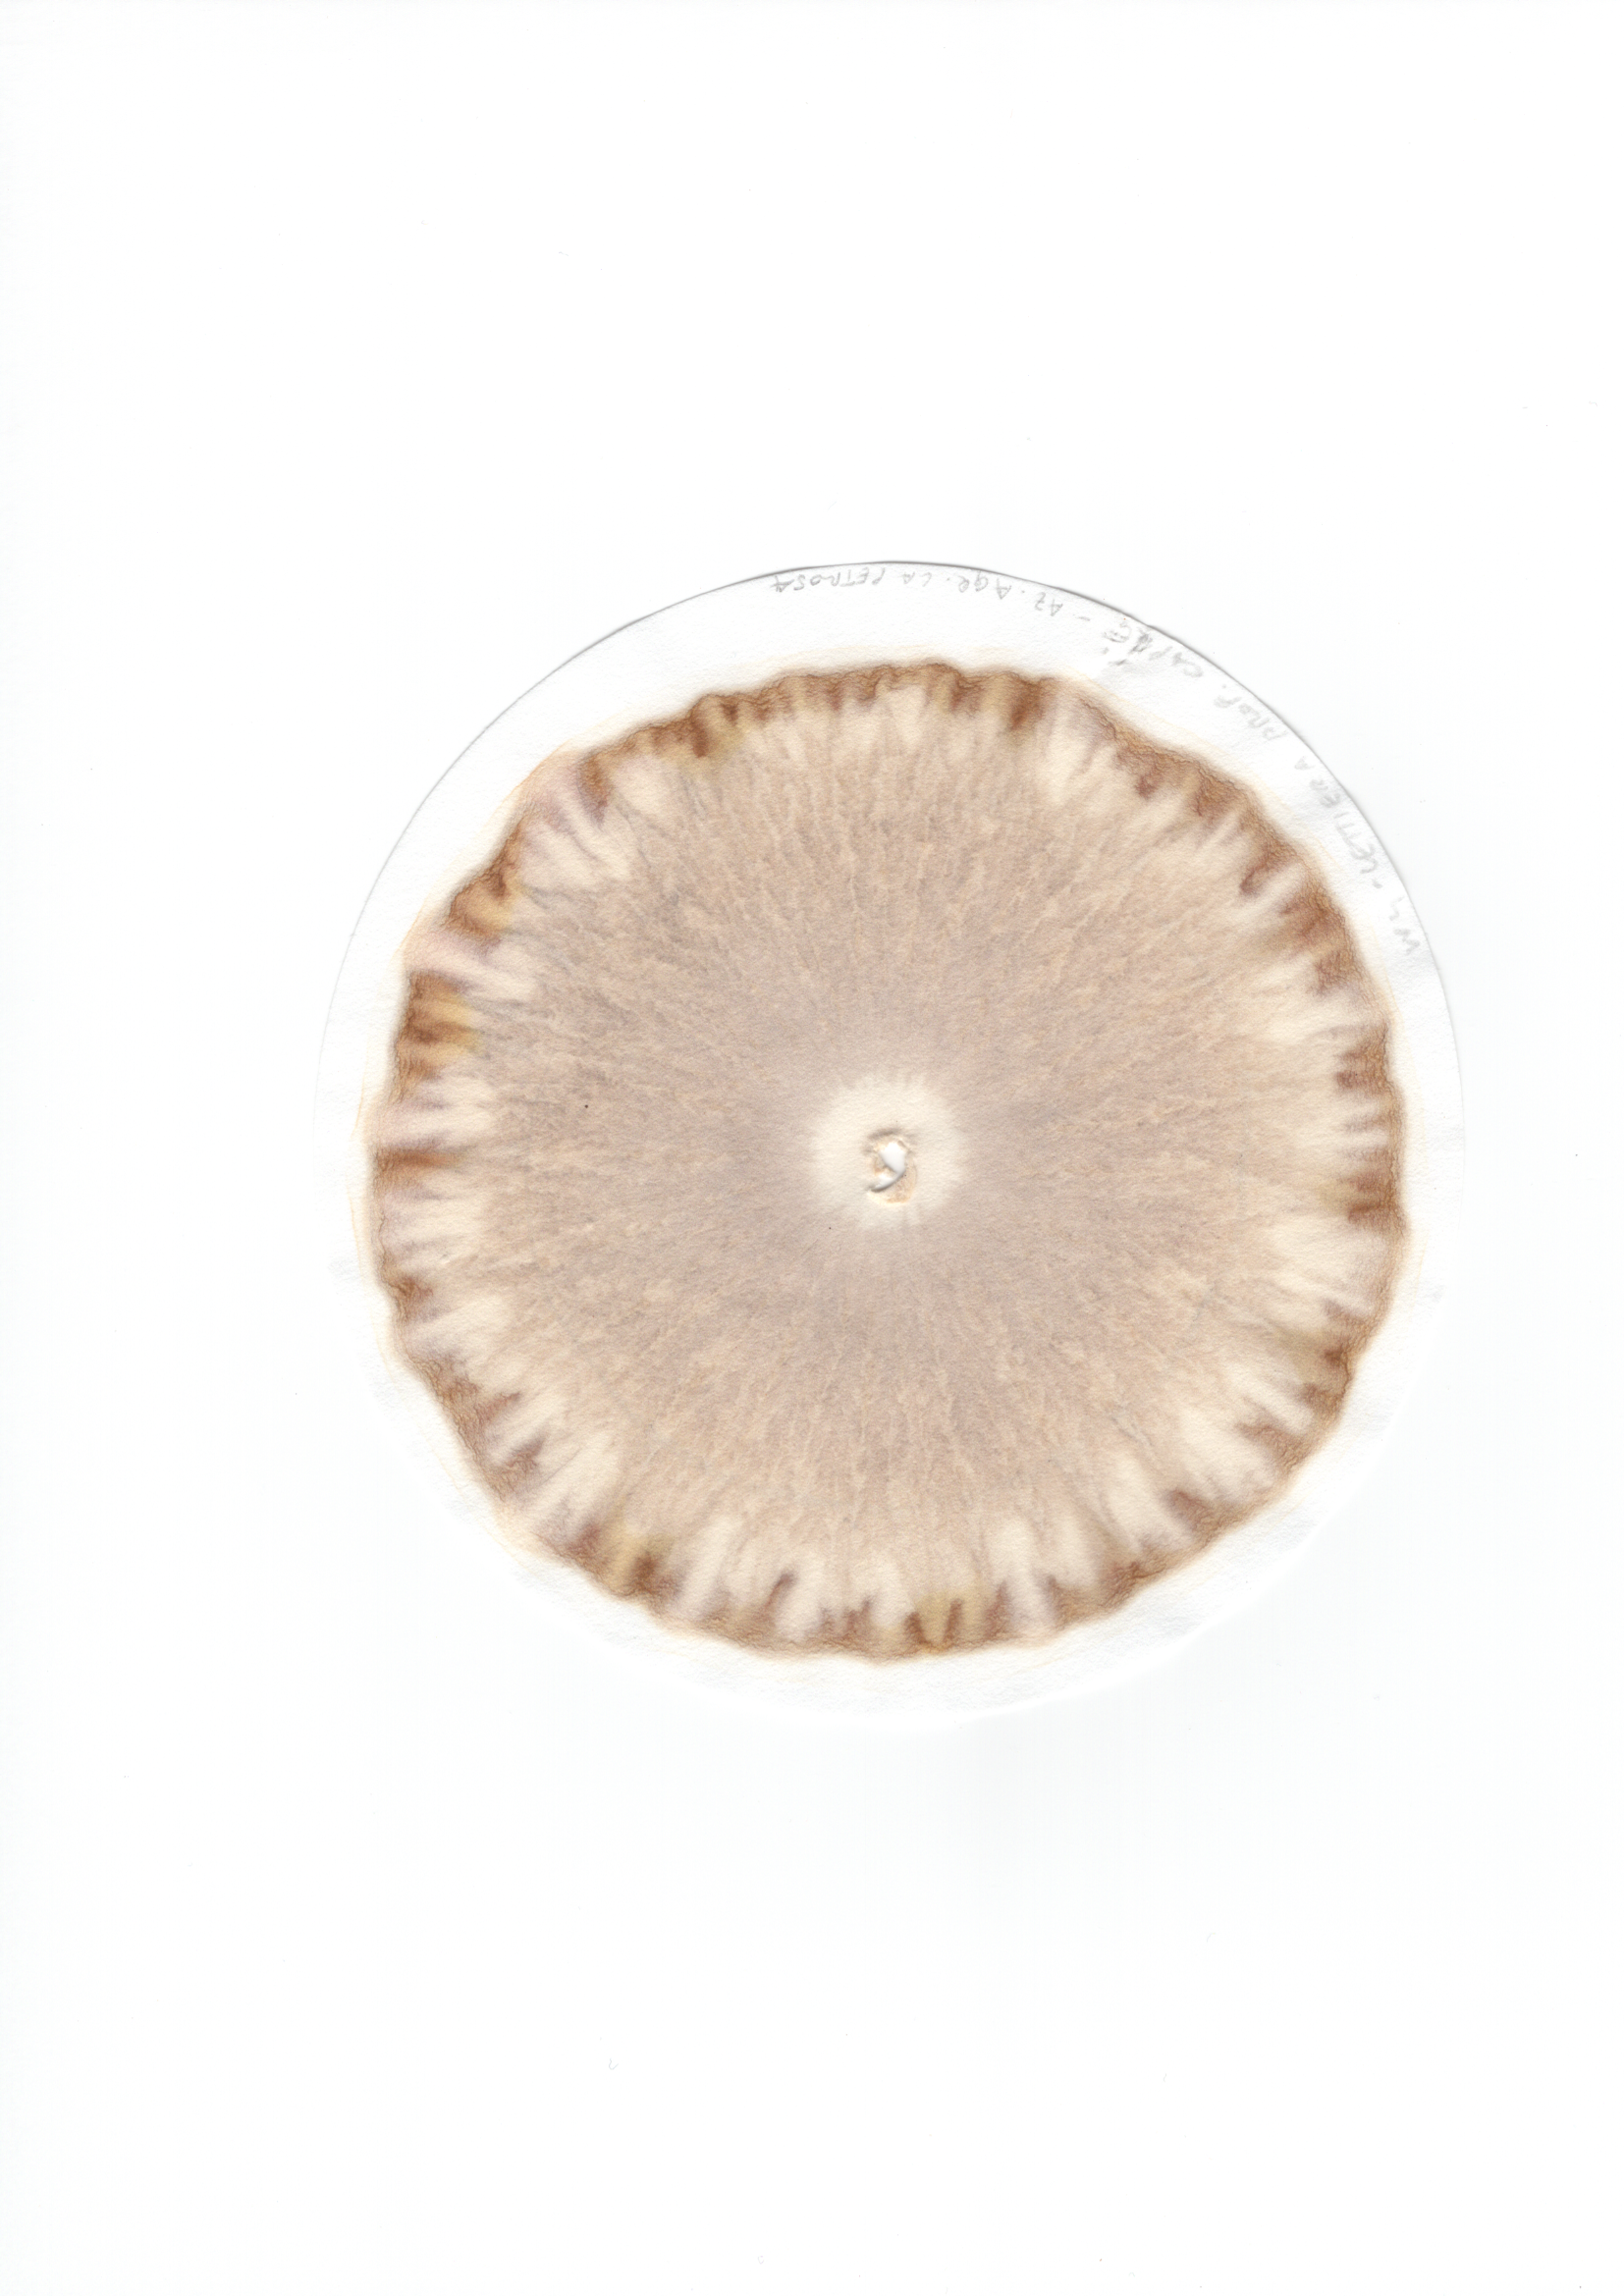

Croma&Arte – Introduzione all’Arte della Cromatografia
a cura di DEAFAL
Può il nostro occhio vedere la fertilità di un suolo?
La cromatografia circolare di Pfeiffer è un’analisi qualitativa per immagini che consente di osservare le condizioni di vitalità dei suoli. Separando i componenti del terreno nel passaggio su carta, viene rivelata, attraverso colori e forme, la complessa vita nascosta nel sottosuolo. Il risultato è un’immagine capace di raccontare la fertilità del suolo, ponendo in dialogo il mondo minerale con quello biologico e manifestando un sorprendente e ogni volta unico linguaggio visivo in cui scienza, ecologia e arte si incontrano.
Oltre al suo valore tecnico-scientifico, la cromatografia del suolo è oggi utilizzata anche come strumento di espressione artistica. Le immagini che emergono dalla separazione delle sostanze presenti nella terra diventano composizioni visive peculiari, capaci di trasformare aspetti scientifici e processi naturali in forme facilmente comprensibili e suggestive.
Attraverso queste immagini possiamo riflettere nitidamente sul rapporto tra l’essere umano e la natura e rendere visibili i possibili impatti sulla salute del suolo, elemento fondamentale per la vita sul pianeta. In questo modo la cromatografia del suolo diventa un’espressione di bioarte, dove i processi naturali partecipano direttamente alla creazione dell’opera.
Attività a numero chiuso, iscrizione consigliata
Per iscrizioni clicca sul pulsante “REGISTRATI ORA“ ☜